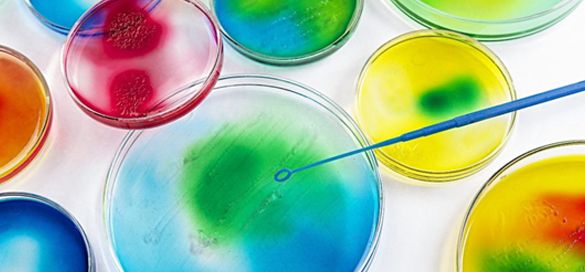

Die Bedeutung der Lokalisierung im Bereich Life Sciences
Welche Kommunikationsziele hat Ihr Unternehmen? Was möchten Sie erreichen?
Bei Janus tun wir alles, um die Kommunikationsziele Ihres Unternehmens innerhalb des festgelegten Finanzrahmens zu erfüllen und schnell zu liefern, damit Sie auch strenge Terminvorgaben einhalten können.
Um unseren Kunden dabei zu helfen, behördliche Hürden zu überwinden, klinische Studien problemlos und einfach zu verwalten und auf dem internationalen Markt erfolgreich zu sein, bieten wir umfangreiche Life-Sciences-Übersetzungen für medizinische Geräte sowie für Unternehmen aus den Bereichen Biotechnologie und Pharmazie.
Wir arbeiten mit führenden Organisationen zusammen, um unseren Kunden erstklassige sprachliche Unterstützung in allen Bereichen zu bieten. Unsere Dienstleistungen werden in der Life-Sciences-Branche geschätzt und sind hoch angesehen; viele führende Unternehmen beauftragen uns mit Übersetzungs- und Dolmetschprojekten in über achtzig Sprachen.
Von der Lokalisierung der Unterlagen zu klinischen Studien und medizinischen Untersuchungen bis hin zu Übersetzungen für medizinische Geräte und von Zulassungsdokumentationen sowie regulatorische Audits – Sie können sich darauf verlassen, dass unser Team aus erfahrenen und qualifizierten Projektmanagern und Übersetzern mit umfangreichem Fachwissen im Bereich Life Sciences die Arbeit in kürzester Zeit und innerhalb Ihres gewünschten Kostenrahmens erledigen wird.
Ein Expertenteam für Ihre Übersetzungen im Bereich Life Sciences
Die Voraussetzung für präzise und qualitativ herausragende Übersetzungen im Bereich Life Sciences ist der Einsatz professioneller, hoch qualifizierter Übersetzer mit umfassendem Hintergrundwissen, die in Medizin- oder Pharmaunternehmen beschäftigt sind oder dort in der Vergangenheit bereits Erfahrungen sammeln konnten.
Wir haben ein umfangreiches Netzwerk an qualifizierten und ausgebildeten Linguisten für zahlreiche Projekte im Bereich Life Sciences aufgebaut. Darüber hinaus verfügen wir über fundierte Kenntnisse über den globalen Life-Sciences-Markt, die länderspezifischen Vorschriften sowie die kommerzielle Lieferkette.
Potenzielle technische Fehler oder Ungenauigkeiten einer Übersetzung werden durch sorgfältige Prüfungen, die ein gründliches Lektorat und das Korrekturlesen Ihres Dokuments beinhalten, beseitigt. Dadurch stellen wir sicher, dass die Übersetzung in der Zielsprache korrekt und leicht verständlich ist.
Wir bemühen uns ebenso, über die neuesten Branchentrends und -entwicklungen auf dem Laufenden zu bleiben, um Ihnen zu garantieren, dass unsere Arbeit genau ist und Ihre Botschaft wunschgemäß vermittelt wird. Wir übersetzen Ihre Kommunikation effektiv und passen sie an den gewünschten Zielmarkt an.
Warum sollten nur Experten Ihre Übersetzungen im Bereich Life Sciences anfertigen?
Im modernen Zeitalter, in dem wir heute leben, sind die Übersetzungen im Bereich Biologie und von Dokumentationen klinischer Studien sowie die Handhabung etwaiger Nebenwirkungen durch strenge Branchengesetze geregelt. Unternehmen müssen sich an viele Datenschutzrichtlinien halten, damit jeder Teil der Übersetzung den Punkt trifft und hundertprozentig korrekt ist.
Beim Übersetzen oder Dolmetschen im Life-Sciences-Sektor ist es wichtig, dass Sie einen vertrauenswürdigen Partner haben, der über Erfahrung und Fachwissen verfügt. Durch unsere langjährige Erfahrung im Umgang mit kritischen und vertraulichen Materialien verfügen wir über ein hochqualifiziertes und zuverlässiges Team kompetenter Übersetzer in zahlreichen technischen Bereichen.
Falsche Übersetzungen oder fehlerhaftes, ungenaues Dolmetschen können in der Life-Sciences-Branche erhebliche Folgen haben, da dadurch wichtige Informationen stark verfälscht werden können, wodurch Ihr Unternehmen gegen strenge Branchenvorschriften verstoßen und Leben gefährden kann. Bei Janus sind wir stolz darauf, nach den folgenden ISO-Normen zertifiziert zu sein, die Ihnen garantieren, dass wir qualitätsorientierte Verfahrensabläufe einhalten. Wir sind derzeit nach ISO 9001:2008, ISO 17100:2015-05 und ISO 13611:2014-12 zertifiziert.

Übersetzungsleistungen im Bereich Life Sciences:
Wir unterstützen Sie bei der Übersetzung der folgenden Inhalte aus dem Bereich Life Sciences:
- Vertrauliche Patienteninformationen
- Patientenstudien
- Protokolle
- Toxikologische Berichte
- Produktetiketten und -beilagen für medizinische Geräte
- Medizinische Schulungsdokumentationen
- Vertrauliche Berichte
- Beiträge in medizinischen Fachzeitschriften
- Webseiten von Unternehmen aus dem Gesundheitswesen
- Unterlagen zum Asset-Management im Gesundheitswesen
- Fragebögen für Teilnehmer
- Klinikverträge
Dolmetschleistungen im Bereich Life Sciences
Wir bieten derzeit die unten aufgeführten Dolmetschleistungen im Bereich Life Sciences an:
- Konsekutivdolmetschen von Einzelgesprächen
- Vertrauliche Aufnahmen aus der Forschung
- Simultandolmetschen auf Konferenzen im Gesundheitswesen
- Dolmetschen bei Telefonkonferenzen
- Dolmetschen bei Gremien für medizinische Forschungsstudien
- Vor-Ort-Dolmetschen bei medizinischen/wissenschaftlichen Präsentationen
Technologie und Lokalisierung im Bereich Life Sciences
Die Welt wird immer schnelllebiger und es gibt immer mehr medizinische Geräte und Technologien, die für Kunden leichter zugänglich sind und zufriedenstellendere Ergebnisse liefern.
Aufgrund der Schnelllebigkeit der heutigen Welt erwarten die Menschen online immer mehr gut definierte und detaillierte Suchergebnisse. Nicht nur unser Lifestyle und unsere Fitness, sondern auch unsere medizinische Gesundheit und unsere Ernährung hängen sehr stark von unserem Wohnort und sozialen Umfeld ab. Obwohl neue personalisierte, datengesteuerte Technologien uns dabei unterstützen, bessere und genauere Ergebnisse zu erzielen, wird die Lokalisierung zu einem Schlüsselfaktor, um diese neuen Technologien den Menschen auf der ganzen Welt zugänglich zu machen. Zum Beispiel wird der Markt für elektronische Patientenakten im Jahr 2019 auf rund 33 Milliarden Dollar geschätzt. Aufgrund dieser Nachfrage benötigen Anbieter und Nutzer eine lokalisierte Technologie für intelligente Software und Apps, die Fehler reduziert und die Daten in einem sichereren und leichter zugänglichen Format zur Verfügung stellt.
Alle medizinischen und pharmazeutischen Unternehmen mit neuen Spitzentechnologien müssen ihre Botschaft durch die sorgfältige Erstellung von Kampagnen, die gezielt und effizient auf die spezielle Zielgruppe in bestimmten Ländern und Regionen ausgerichtet sind, verbreiten.
Durch Programme wie die BRAIN-Initiative, bei der es sich um ein großangelegtes Projekt zur Förderung von Technologien und Unternehmen handelt, die sich mit der Behandlung von Krankheiten wie Hirnverletzungen, Epilepsie und Schizophrenie befassen, wird es zunehmend notwendig werden, diese Produkte und Behandlungen zu lokalisieren, damit sie in Zukunft für alle zugänglich sind.
Heutzutage gibt es viele mobile Apps im Gesundheitsbereich, die alles von der Überwachung täglicher Fitnessaktivitäten, dem Kalorien- und Schrittzähler bis hin zum EKG des Arztes über das Smartphone anbieten. Durch intelligente Gamifizierung dieser Apps und die vielen Nutzer, die online nach Ratschlägen suchen und diese Apps verwenden, um eine Antwort auf ihren Gesundheitszustand zu finden, ist es entscheidend, dass es in jeder Sprache Zugang zu diesen Informationen gibt. Angesichts der globalen Gesundheitsausgaben, die bis 2020 8,7 Billionen Dollar erreichen können (Angaben laut Deloitte), können wir sicher sagen, dass dieser Markt und die gesamte digitale Landschaft der Life Sciences und des Gesundheitswesens auf vertrauenswürdige und fähige Lokalisierungsanbieter zurückgreifen müssen, die auch neue Technologien einsetzen, um die Genauigkeit und Geschwindigkeit der Lokalisierung zu verbessern.